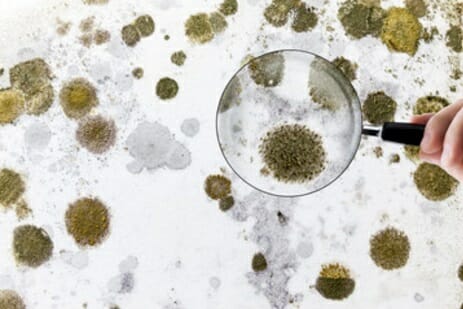

News お知らせ
-

夏季休業のおしらせ【2025】
-

泉田4丁目分譲住宅のオススメポイント!
-

年末年始休業のおしらせ
-

岡山で美味いうどんが食べたい 番外編その3
-

岡山で美味いうどんが食べたい 番外編その2
-

【百聞は一見にしかず】遮熱材vs断熱材ガチンコ対決
-

岡山で美味いうどんが食べたい 番外編
-

今さら聞けない、断熱材と遮熱材の違いって???
-

岡山で美味いうどんが食べたい その25(讃岐も近いしね)
-

ショールーム見学へ行ってきました
-

神様の海岸へ行こう!!
-

多数のご来場ありがとうございました♪コンクリート住宅見学会
-

【遮熱材の素晴らしさ】断熱材だけが万能のウソ!?
-

南中央町マンション完成!
-

完成間近! 施工中8階建マンション!!
-

施工中 8階建マンション! 時々釣り
-

住宅ローンへの不安・・・いくら借りる?
-

岡山で美味いうどんが食べたい その24(讃岐も近いしね)
-

岡山で美味いうどんが食べたい その23(讃岐も近いしね)
-

岡山で美味いうどんが食べたい その22(讃岐も近いしね)
-

岡山で美味いうどんが食べたい その21(讃岐も近いしね)
-

2世帯住宅をお考えの方へ~完全分離型2世帯住宅ってどう?~
-

岡山で美味いうどんが食べたい その20(讃岐も近いしね)
-

岡山で美味いうどんが食べたい その19(讃岐も近いしね)
-

岡山で美味いうどんが食べたい その18(讃岐も近いしね)
-

フローリングのお掃除をますますラクにするグッズ紹介!からのなぜか「キッチンの豆歴史」
-

\福富西2丁目新築分譲住宅/完成見学会開催
-

去年から始めました・・・で、なにを?
-

住宅購入にとってとても大事な住宅ローンのあれこれ~その2~
-

住宅購入にとってとても大事な住宅ローンのあれこれ~その1~
-

被災地の一刻も早い復興をお祈りしていますm(_ _)m
-

あけましておめでとうございます。
-

表町さんぽ④~食堂やまと~
-

なぜRC住宅を建てたのですか?災害に強い家を建てたい!T様の場合
-

1月14日はコンベックスでマイホーム計画を前進させよう!
-

悩んじゃう!クロス決めのコツをお話します。
-

表町さんぽ③~手打ちうどん「たぬき」~
-

年末年始休業のおしらせ
-

【マイホームをお考えの方必見】~家造りに外せないお金の問題と向き合う その2~
-

猫を飼いたい方にオススメ物件
-

表町さんぽ② ~大勝さんで煮干しラーメン~
-

【マイホームをお考えの方必見】~家造りに外せないお金の問題と向き合う~
-

インフレの影響はどうなる?~住宅市場の行方~
-

表町さんぽ① ~milletさんでランチ~
-

芳泉小学校まで徒歩5分!の新築分譲住宅での暮らしを妄想してみました。
-

夏季休業のお知らせ
-

とある現場と、とあるお蕎麦屋さん。
-

泉田4丁目分譲住宅【外壁工事の様子】
-

活気あふれる上棟の様子&見えない床下をお見せします!泉田4丁目分譲住宅工事の様子
-

【発表します!】今我々が『分譲住宅』を建てる理由!
-

泉田4丁目の分譲住宅、外観を初公開!
-

芳泉学区で分譲住宅の工事が始まりました
-

なぜコンクリート住宅を建てたのですか?
-

知ってました?コンクリートでできた腕時計
-

施工事例⑬ あなたも住みたくなる!おしゃれで解放感のあるコンクリート住宅
-

コンクリートを食べる生き物たち
-

年末年始休業日のお知らせ
-

コンクリート打ちっ放しにもベストマッチ!木とアイアンを使ったブラケットライト
-

1つ1つ手作り!やさしく温かい印象のペンダントライト
-

【まとめ】大人気のモルタル仕上げのカウンターについて
-

除菌消臭に!オゾン発生器付小型シーリングが新発売
-

ベランダやバルコニーは必要?不要?
-

FUGAの調光ロールスクリーン、お客様に大好評!
-

ズバリお伝えします!コンクリート住宅の魅力!サンオリエントの注文住宅Q&A
-

希望の土地を希望の時期までに手に入れるコツ ③/3
-

希望の土地を希望の時期までに手に入れるコツ ②/3
-

一体どこまで?【建築費高騰】の行方~答えは○○にあり!?~
-

【トレンド情報】アメリカを中心に「白いドア」と「黒いハンドル」が流行の兆しを見せているらしい
-

夏季休業のお知らせ
-

参考になる!アクセントクロスの使い方~7/30-8/1の見学会でご覧いただけます~
-

モルタル仕上げのカウンター制作中!実物が見たい方は7月の見学会で!
-

希望の土地を希望の時期までに手に入れるコツ ①/3
-

何年ぶり?お施主様との懇親会
-

店舗兼用住宅の工事が進んでいます♪
-

どうしてもうまく言葉で伝えられない・・・(T_T)
-

店舗兼用住宅の建築が始まってます♪
-

サンオリエント新体制構築のご報告
-

二つのアーバンテラス、完成間近!!
-

コンクリートの未来
-

木造住宅とコンクリート住宅のメリット・デメリット。サンオリエントの注文住宅Q&A
-

毎年恒例となった『私のほうふ』
-

新年明けましておめでとうございます! From:磯崎
-

年末年始休業日のお知らせ
-

施工事例⑫ 注文住宅で二世帯同居のコンクリート住宅
-

コンクリート住宅の住み心地はいかがですか?
-

世間話も大切ですね♪
-

漆喰のメリット・デメリット。サンオリエントの注文住宅Q&A
-

夏季休業のお知らせ
-

夏季休業のお知らせ
-

ふたつのアーバンテラス(賃貸マンション)【後編】
-

身近なところから朗報有り(^o^)
-

ふたつのアーバンテラス(賃貸マンション)新築工事がスタートしました!【前編】
-

サンオリエントが選ばれる5つの理由
-

これ何のことだか分かります? 『ラーメン構造』VS【壁式構造】
-

施工事例⑪ 幻の漆喰を使ったおしゃれな新築木造住宅
-

3.11から10年 追悼と共に自分達の存在価値を問う!
-

完成見学会のお知らせ 2021年3月
-

新築住宅、内装におすすめの塗り壁教えます!サンオリエントの注文住宅Q&A
-

吹抜けってどう?
-

岡山の木造住宅なら!延床面積約28坪・3LDK+和室/使いやすい家事動線や間取りが特徴。サンオリエントの間取りプラン紹介No.103
-

コンクリート打ちっぱなしがクールな住宅、進行中です
-

施工事例⑩:カフェみたいなリビング!『新築木造住宅』
-

謹賀新年 あけましておめでとうございます!
-

コンクリート住宅と木造住宅の建ち始めはちょっと違います。
-

ハウスメーカー、工務店、大工さん・・・家を建てるならどこがいい?サンオリエントの注文住宅Q&A
-

岡山の木造住宅なら!延床面積約22坪・2階にはフリースペース/コンパクトでリーズナブル!サンオリエントの間取りプラン紹介No.102
-

取材をうけて記事にしてもらいました!
-

施工事例⑨:スキップフロアの鉄骨住宅
-

ステキなウォークインクローゼットができました。
-

〇〇を二つ作ろう!二世帯住宅の間取りを決める時の注意点。サンオリエントの注文住宅Q&A
-

色柄のある壁紙を選ぶって、どうですか?
-

2020年 夏季休業のお知らせ
-

施工事例⑧:アイランドキッチンのある2階リビング『新築木造注文住宅』
-

【続報】今度は日本経済新聞に! 我が社のRC住宅への取り組みが記事になりました(^_^)
-

新築デザイナーズ分譲住宅&売土地情報~岡山市南区泉田~
-

【速報】我が社のRC住宅への取り組みが山陽新聞に取り上げられました!
-

後悔したくない!注文住宅の間取りを決める時の注意点。サンオリエントの注文住宅Q&A
-

グラフテクトのショールームへ行ってきました
-

家事や育児にかける時間をもっともっと節約したい人はいませんか?
-

すりガラスは夜、外からホントに見えないの?
-

施工事例⑦:優れた断熱性能!外断熱の家『新築一戸建てRC住宅』
-

RC住宅のお宅紹介! 動画でのレポート【後編】
-

固定金利?変動金利?住宅ローンを組む時の注意点!サンオリエントの注文住宅Q&A
-

RC住宅のお宅紹介! 動画でのレポート【前編】
-

コンクリート住宅ができるまで 【動画でお届けします!】
-

岡山市立富山小学校内児童クラブ新築工事の完成写真、更新しました!
-

施工事例⑥:コンクリート打ちっ放しのテイストをいれた新築木造住宅
-

まず生き残れ。儲けるのはそれからだ!~経営者としての仕事~
-

新たなRC住宅のプロジェクトがスタート!!
-

家づくりを我慢しない秘訣とは?予算を決めた後にすること。サンオリエントの注文住宅Q&A
-

収益物件/新築木造アパート「アーバンテラス東岡山」完成しました!
-

【お役立ち情報】「シックハウス症候群対策ってどうなってるの?」連載コラムその15-2
-

【お役立ち情報】「シックハウス症候群対策ってどうなってるの?」連載コラムその15
-

新型コロナウイルスが暴いた事実~住宅ローンに要注意!!
-

施工事例⑤:おしゃれなコンクリート打ちっ放し住宅『新築RC注文住宅』
-

収納スペース足りるかな?洋服の整理と処分方法について
-

不動産投資は危険なのか?? 新しく完成した物件で説明します!!
-

注文住宅の自己資金はどれくらい必要?マイホームを建てる時の注意点!注文住宅Q&A
-

家の臭い対策するなら、オゾネオ!インフルエンザ対策にも
-

新着RC住宅情報!! 「百聞は一見にしかず」画像をお楽しみ下さい(^_^)
-

初めてのマイホーム!注文住宅を考えているなら〇〇から検討しよう!
-

大盛況!めずらしいコンクリート住宅の完成見学会
-

施工事例④:低コストで防音室完備!『新築一戸建て木造住宅』
-

明けましておめでとうございます! From:磯崎
-

こんなRC住宅が欲しかった!コンクリートの素材感満載の家
-

あなたはどんな家に住みたいですか?施工事例③『新築一戸建て木造住宅』
-

【お役立ち情報】「シックハウス症候群の原因あれこれ」連載コラムその14-2
-

【お役立ち情報】「シックハウス症候群の原因あれこれ」連載コラムその14-1
-

あなたはどんな家に住みたいですか?施工事例②『新築一戸建て木造住宅』
-

新築完成見学会 コンクリート住宅 小田郡矢掛町
-

現場にいる職人さんから突然電話が・・・そのワケは??「社長、すみません!たいした用事じゃ無いんですが・・・」
-

あなたはどんな家に住みたいですか?施工事例①『新築一戸建て木造住宅』
-
【お役立ち情報】「シックハウス症候群の対策は??」連載コラムその13-2
-

【お役立ち情報】「シックハウス症候群の対策は??」連載コラムその13-1
-

コンクリート住宅建築中~矢掛町T様邸②~&矢掛の大名行列
-

来年の手帳は何にしよう?~出版社が作るダイアリーは使いやすい~
-

コンクリート住宅建築中~矢掛町T様邸~
-

間取りと色を選んで建てる家。打合せ回数が減らせるので時間がない方におすすめの「コンセプトハウス」
-

インテリアのプロが選ぶ学習机はコレ!~女の子用~
-

セメントでフォトスタンドを作ったよ~HUGHUGワールド2019でプレゼント~
-

【お役立ち情報】「で、そもそもシックハウス症候群ってなに??」連載コラムその12-2
-

【お役立ち情報】「で、そもそもシックハウス症候群ってなに??」連載コラムその12-1
-

★7月27日・7月28日 岡山市中区で住宅完成見学会★
-

はじめての家づくりのヒント~洋服を選ぶように~
-

【完成見学会】~時間をかけずに建てる家~ 岡山市中区
-

私が住宅ローン借換を決断した理由
-

【お役立ち情報】「新築住宅+ホルムアルデヒド=シックハウス症候群」連載コラムその11
-

6月26日現場進捗状況です
-

岡山市北区磨屋町のクロスオーバーさんでガレットを食べてきました
-

【お役立ち情報】「アレルギーに漆喰が効く???」連載コラムその10
-

岡山の木造住宅なら!延床面積約33坪・3LDK・2Fリビング/使いやすい家事動線や間取りが特徴。サンオリエントの間取りプラン紹介No.101
-

始まりと終わり!?
-

ヤバイ!団信に入れないかも!って焦った話
-

岡山市中区福泊 M様邸新築工事 進捗状況
-

新しい現場始まりました!
-

【お役立ち情報】「リフォームで漆喰壁にしたい!そんな時は・・・」連載コラムその9
-

4月29日30日・岡山市中区福泊で見学会!光熱費を下げる秘密は構造にあり!?サンオリエントの間取りプラン紹介No.100
-

【お役立ち情報】「まさか漆喰の壁にカビが!!そんな時どうすれば?」連載コラム その8
-

来春は行ってみて!穴場お花見スポット
-

岡山の木造住宅なら!延床面積約28坪・3LDK/使いやすい家事動線や間取りが特徴。サンオリエントの間取りプラン紹介No.99
-

”光熱費を節約できる家”遮熱体験会&売地情報in岡山市中区福泊
-

【お役立ち情報】「使ってみたい漆喰、でも漆喰のデメリットとは?」連載コラム その7
-

「寒いのはイヤだ!」体がよろこぶリフォームしませんか!?
-

【お役立ち情報】「再び注目を浴びる漆喰~住宅に使うメリットとは?」連載コラム その6
-

地鎮祭って、どんなことするの?準備は?
-

【お役立ち情報】「乾燥していない木はなぜいけない?」連載コラム その5
-

岡山で鉄筋コンクリート住宅を建てるならサンオリエントへ!RC造マンションの施工実績追加しました!
-

工事完成しました。
-

ボダムのグラスは大活躍しそう♪
-

実況!! 皇居清掃奉仕日記 「最終日」 2019年2月21日
-

実況!! 皇居清掃奉仕日記 「大感動のご会釈」2019年2月19日
-

実況!! 皇居清掃奉仕日記 2019年2月20日
-

【お役立ち情報】連載コラム その4 「木造住宅を建てるのはどれくらいの時間が必要?」
-

実況!! 皇居清掃奉仕日記 2019年2月18日
-

岡山の木造住宅なら!延床面積約24坪・2階リビング/コンパクトでリーズナブル!サンオリエントの間取りプラン紹介No.98
-

【お役立ち情報】連載コラム その3 「木造住宅の特徴は日本の気候風土に適しているの?」
-

【お役立ち情報】連載コラム その2 「木造住宅の寿命が30年は本当!?」
-

【お役立ち情報】連載コラム その1 「木造住宅のメリットとデメリット」
-

人気のK様邸へ1年点検に行ってきました。
-

岡山の木造住宅なら!延床面積約22坪・1LDK/コンパクトでリーズナブル!サンオリエントの間取りプラン紹介No.97
-

家づくりで家族の意見がまとまらない!そんな時は、、、
-

岡山市北区 学南町2丁目アパート新築工事 外部・内部仕上工事進捗状況
-

嘘つき政府の大バカヤロー ~新築住宅を建てたい人を悩ますZEHの行く末~
-

タカラ岡山ショールームへ行ってきました
-

先週、4歳の娘に教えられてドキッとした話
-

岡山の木造住宅なら!延床面積約27坪・2LDK+S/コンパクトでリーズナブル!サンオリエントの間取りプラン紹介No.96
-

新築構造見学会開催~岡山市中区湊~平屋の家
-

岡山市北区 学南町2丁目アパート新築工事 躯体工事進捗状況
-

【続報】花粉症に効く『幻の漆喰』
-

近藤典子先生「片づく家のつくり方」セミナーに行ってきました
-

岡山市北区 学南町2丁目アパート新築工事 1階躯体工事
-

【花粉症に効く!!】 当社オススメの幻の漆喰が快挙(^o^)
-

岡山の木造住宅なら!延床面積約25坪・2LDK/コンパクトでリーズナブル!サンオリエントの間取りプラン紹介No.95
-

10月24日 岡山市中区注文住宅現場進捗状況
-

カビの発生を招く恐ろしい結露(>_<) 結露を呼ぶちょっとしたミスを犯さない方法
-

1年後のお客様の声 木造注文住宅 倉敷市T様邸
-

岡山市北区 学南町2丁目アパート新築工事 進捗状況です!
-

遂にきたか消費税増税(>_<) 今から始まる住宅争奪戦に対処する方法
-

岡山の木造住宅なら!延床面積約24坪・3LDK/屋上テラスやグリーンゲージ。サンオリエントの間取りプラン紹介No.94
-

【就職希望の君へ】 その1 自己紹介
-

木造住宅業界を席巻する「透湿シート+通気工法」ホントにこれが良いの??
-

猫のトイレはどこがいい?
-

豪雨被害で被災された方へ 被災者支援の内容をまとめてみました!
-

岡山市北区磨屋町で施工した店舗の改装工事の施工実績追加しました!
-

8月29日 現場進捗状況
-

RCと鉄骨…アトリエのある芸術家の住まい②
-

地域の活性化に必要な事とは? 建築に関する事例で考えてみる
-

【ご協力ありがとうございました!!】 被災された方々へ 想いよ届け!!のその後
-

岡山の木造住宅なら!延床面積約38坪・5LDK/スキップフロアでたっぷり収納。サンオリエントの間取りプラン紹介No.93
-

2018年夏季休業のお知らせ
-

岡山市津倉町M様邸新築工事 外構工事完了しました!
-

岡山の木造住宅なら!延床面積約33坪・4LDK/使いやすい家事動線や間取りが特徴。サンオリエントの間取りプラン紹介No.92
-

【自然に優しい太陽光発電】は本当??当社がお薦めしないワケ
-

浸水災害で被災された方々へ。 想いよ届け!!その2
-

岡山の木造住宅なら!延床面積約37坪・2LDK/使いやすい家事動線や間取りが特徴。サンオリエントの間取りプラン紹介No.91
-

建築士として被災された方に出来る支援を考えた・・・
-

浸水災害で被災された方々へ。 想いよ届け!!
-

あなたの家づくりの知識はどのくらい?
-

今回の豪雨災害で被災された方々へ『私たちが出来ること』
-

お客様の疑問・質問 ダントツのNo.1はこれだ!!その3
-

家事ラクグッズ~3COINSの平干しネット~
-

6/27 工事進捗状況 岡山市 南区 北区
-

お客様の疑問・質問 ダントツのNo.1はこれだ!!その2
-

岡山の木造住宅なら!延床面積約32坪・2LDK+畳コーナー/使いやすい家事動線や間取りが特徴。サンオリエントの間取りプラン紹介No.90
-

岡山市津倉町M様邸新築工事 内装工事も終わり完成まであとわずかとなりました!
-

お客様の疑問・質問 ダントツのNo.1はこれだ!!
-

岡山の木造住宅なら!延床面積約約37坪・2階リビング・北道路/使いやすい家事動線や間取りが特徴。サンオリエントの間取りプラン紹介No.89
-

岡山市津倉町M様邸新築工事 内部・外部工事進捗状況
-

ベストな対面キッチンのカウンター高さは?
-

ニュースに出ました!! KSB瀬戸内海放送「スーパーJチャンネル」
-

リフォームの6か月検査にお伺いしました
-

岡山の木造住宅なら!延床面積27坪・2LDK/コンパクトでリーズナブル!サンオリエントの間取りプラン紹介No.88
-

岡山市津倉町 M様邸新築工事 内部造作・下地工事進捗状況
-

ニュースにでます!! KSB瀬戸内海放送「スーパーJチャンネル」見てね!!
-

ご新居の住み心地は?半年検査におうかがいして
-

GW工事進捗状況
-

~星に願いを~ 「サンオリエント誕生秘話」 その5(最終回)
-

岡山の木造住宅なら!延床面積約25坪・1LDK/コンパクトでリーズナブル!サンオリエントの間取りプラン紹介No.87
-

~星に願いを~ 「サンオリエント誕生秘話」 その4
-

~星に願いを~ 「サンオリエント誕生秘話」 その3
-

耐震等級って?我が家には必要かを考えてみませんか?
-

岡山市津倉町 M様邸新築工事 週末に構造見学会を控えた現場の進捗状況です!
-

~星に願いを~ 「サンオリエント誕生秘話」 その2
-

山陽新聞に記事が掲載されました!! 【鉄筋コンクリートでマイホームを建てる】
-

構造見学会開催~岡山市北区津倉町~
-

磨屋町BAR 改修工事 CROSSObar完成
-

~星に願いを~ 「サンオリエント誕生秘話」 その1
-

岡山市津倉町 M様邸新築工事 基礎工事完了~週末には上棟です!
-

岡山の木造住宅なら!延床面積約37坪・4LDK+和室/自然派ライフスタイルの方におすすめ!サンオリエントの間取りプラン紹介No.86
-

当社のお客様との連絡は? 4/4現場進捗状況 磨屋町
-

三匹の子ブタが教えてくれたコト ~ナゼおとうと子ブタが二人の兄を救えたのか?~
-

土地探しの秘訣とは?~岡山で家を建てる~
-

岡山市津倉町 M様邸新築工事 工事進捗状況
-

【鉄筋コンクリートでマイホームを建てる】 出版でーす(^^)/
-

土地活用をご検討中の方!2月に開催いたしました完成見学会の賃貸マンションの施工実績追加しました!
-

ついについに!!本の出版が目前に迫りました(^o^)
-

きっかけは資料請求。RCと鉄骨…アトリエのある芸術家の住まい
-

芳泉小学校区にちょっといや、かなり気になる売り地が・・・ 自宅の新築をお考えのアナタにご紹介します!!
-

岡山の木造住宅なら!延床面積約26坪・2LDK/自然派ライフスタイルの方におすすめ!サンオリエントの間取りプラン紹介No.85
-

工事進捗状況3/7 北区京山 注文住宅・磨屋町 店舗
-

これぞプロの技[僕の事じゃないよ!(>_<)] 新築賃貸マンションの完成写真出来ました!!
-

洗濯がラクになる間取り
-

3月から新しく始まる工事は?注文住宅?店舗?
-

アーバンテラス川崎医大南完成見学会@中庄 無事終了
-

岡山の木造住宅なら!延床面積約30坪・3LDK/屋上テラスやグリーンゲージ。サンオリエントの間取りプラン紹介No.84
-

県営住宅山陽団地ストック総合改善工事 外部足場解体中です!
-

学生向け賃貸マンション 完成見学会 倉敷市中庄
-

今度の地鎮祭はあのタコ公園の近く(^o^) 岡山市で新しい注文住宅の新築が始動です!!
-

ラクでおしゃれなお掃除グッズ「Mi Woolloes(ミーウーリーズ)」
-

工事進捗状況 完成 和気クリーンセンター
-

ボンビーガールも幸せにしてくれる遮熱材! 森泉ちゃんも「リフレクティックス」を貼ってました【テレビで】(^o^)
-

岡山の木造住宅なら!リフォームもお任せください。内装全面リフォームの施工実績追加しました!
-

注文住宅だけじゃないサンオリエントのお仕事とは?
-

キッチンの引き出しを直しにチョイと総社まで~メンテナンス紀行~
-

岡山の木造住宅なら!延床面積約24坪・3LDK/2Fリビング。サンオリエントの間取りプラン紹介No.83
-

木造?鉄骨?RC?? 構造の差は何なの?? 迷ったときはご相談下さい!!
-

岡山の木造住宅なら!延床面積約32坪・3LDK/植栽を楽しむバルコニー。サンオリエントの間取りプラン紹介No.82
-

県営住宅山陽団地ストック総合改善工事 進捗状況!
-

工事進捗状況1/10 和気クリーンセンター・山陽団地
-

2018 年末年始休業のお知らせ
-

子供がグングン育つ家リフォームで実現!! 岡山市北区で中古住宅購入からのリフォーム
-

岡山の木造住宅なら!延床面積約30坪・3LDK/屋上テラスやグリーンゲージ。サンオリエントの間取りプラン紹介No.81
-

One&Onlyなお部屋造りを目指すアナタへ!!岡山で住宅の新築をお考えなら耳寄り情報をお届けします(^o^)
-

まもなく完成!O様邸リフォーム(岡山市北区)
-

工事進捗状況12/13 和気クリーンセンター
-

岡山の木造住宅なら!10月に開催いたしました完成見学会のお宅の施工実績追加しました!
-

工事進捗状況12/6 和気クリーンセンター
-

【予約満室御礼】 賃貸経営のススメ!賢い大家さんになるには?(^^)/
-

「岡山県岡山市 N様邸 リフォーム」
-

意外と知らない?と言うか業界人でもほとんど知らない(>_<)住宅の遮熱と断熱の仕組みの違い
-

火事だけじゃない!こんなことにも対応!火災保険
-

工事進捗状況11/22 和気クリーンセンター・山陽団地
-

【建もの探訪】ならぬ「お宅探訪」 岡山市京山学区での新築住宅が竣工!! 見たい??
-

岡山の木造住宅なら!7月と8月に開催いたしました完成見学会のお宅の施工実績追加しました!
-

今度は障害者支援施設だ!!住宅だけじゃない賃貸だけでもない@岡山の建築屋さん
-

遮熱材が岡山を救う??さらば熱中症!! 「遮熱材の効果・断熱材と比べてみると」 連載コラムその23
-

注文住宅のお引渡しでした♪~岡山 京山学区~
-

工事進捗状況11/7 和気クリーンセンター・山陽団地
-

雨にもマケズ、台風にもマケズ! 完成見学会への参加ありがとうございました(^o^) 新築注文住宅@岡山
-

岡山の木造住宅なら!延床面積約27坪・3LDK/屋上テラスやグリーンゲージ。サンオリエントの間取りプラン紹介No.80
-

岡山市 新築木造注文住宅完成! 他工事進捗
-

岡山市 新築木造注文住宅完成! 他工事進捗
-

住宅用地の確保でお悩みの方必見!!「土地共同購入って何だ?」 かしこい新築注文住宅の建て方@岡山
-

待ちに待った!外観がお目見え♪~京山学区の新築住宅~
-

岡山市 新築木造注文住宅 公共工事 他 10/18 進捗状況
-

その先にある大切な物~ 営業下手な社長が繰りだす「建てるな」の意味とは??
-

岡山の木造住宅なら!延床面積約32坪・3LDK/スキップフロアでたっぷり収納。サンオリエントの間取りプラン紹介No.79
-

デザイナーズ住宅にあこがれる? 多彩なデザインを可能にするRC住宅! 連載コラムその22
-

新築完成見学会開催~岡山市京山学区~
-

岡山市 新築木造注文住宅 船穂リフォーム 他 10/4 進捗状況
-

俺たちの仕事は最高だ!! 雨にも負けぬイカす職人さん達に囲まれた現場はいかが??
-

岡山の木造住宅なら!延床面積28坪・3LDK/スキップフロアでたっぷり収納。サンオリエントの間取りプラン紹介No.78
-

RCは高い!!は本当なの?? 長く住んだらお得になるのか?? 連載コラムその21
-

「好き!」を集めてまとまりのあるインテリアに~岡山市北区のリフォーム~
-

岡山市 新築木造注文住宅 船穂リフォーム 社員寮基礎 他 9/20 進捗状況
-

良い会社ってどんな会社??→→当社の目指す良い会社はこんな会社!!
-

岡山の木造住宅なら!延床面積約32坪・3LDK/使いやすい家事動線や間取りが特徴。サンオリエントの間取りプラン紹介No.77
-

掘って掘って掘りまくれ!!←うそ、あんまり掘り過ぎちゃダメだよ(^_^;)
-

見せる収納アイデアとコツ~岡山県総社市Y様邸~
-

岡山市 新築木造注文住宅 船穂リフォーム 社員寮基礎 進捗状況
-

祝!携帯発見(^_^)v じゃなくて祝!!お引き渡し!!
-

岡山の木造住宅なら!延床面積約32坪・3LDK+和室/使いやすい家事動線や間取りが特徴。サンオリエントの間取りプラン紹介No.76
-

岡山市 新築木造注文住宅 社員寮基礎 8/30 他 進捗状況
-

何年もつんだコンクリート?? RC造の住宅の寿命目安と必要なメンテナンス
-

岡山の木造住宅なら!延床面積約35坪・北道路/使いやすい家事動線や間取りが特徴。サンオリエントの間取りプラン紹介No.75
-

岡山市 新築木造注文住宅 社員寮基礎 8/23 他 進捗状況
-

すべてがア・ツ・イ 猛暑の中の完成見学会!!@倉敷市船穂町 木造新築住宅
-

生活しやすくオシャレな家ってどんな家?見学会で体感♪
-

エスパス岡山 高圧引込線改修に伴う足場工事です
-

フツウの家じゃつまんない!RC住宅に興味のある方!必見の完成見学会@倉敷市船穂
-

岡山市 新築木造注文住宅 社員寮基礎 他 8/2進捗状況
-

お客様におこられました・・・ 「もっと有名になってみんなの家造りを手がけないとダメだよ!」
-

構造見学会開催&売地情報@人気の京山学区!岡山市北区津倉町
-

オシャレな室内ドアってどんなドア?
-

岡山市 新築木造注文住宅 社員寮基礎 他 進捗状況
-

*地震大国日本* RC造住宅の耐震性と地盤の関係 連載コラムその19
-

岡山の木造住宅なら!延床面積約30坪・2LDK+WIC/使いやすい家事動線や間取りが特徴。サンオリエントの間取りプラン紹介No.74岡山
-

岡山市北区 京山 新築木造注文住宅 他 進捗状況
-

アナタも気になる? どんな人がどうやって家造りをしているのか?? 統計をご紹介します!!
-

総社・岡山 新築木造 注文住宅 進捗状況 基礎工事開始?
-

総社での新築住宅完成見学会 ご来場ありがとうございました!!
-

「新築完成見学会」@岡山県総社市総社にて
-

大事なことを言い忘れていました(>_<)
-

総社・岡山 新築木造 注文住宅 進捗状況 旭操小学校完成
-

今週末 8日~9日総社市で開催する新築注文住宅の完成見学会にぜひお越し下さい!!
-

岡山県倉敷市注文住宅T様邸新築工事 階段が架かりました!
-

岡山県総社市新築完成見学会「インダストリアルテイストの家」
-

総社・岡山 新築木造 注文住宅 旭操小学校 進捗状況
-

岡山の木造住宅なら!延床面積約30坪・2LDK/北側道路の旗竿地専用。サンオリエントの間取りプラン紹介No.73
-

RC住宅の特徴とメリット・デメリット 連載コラムその18
-

岡山県倉敷市木造注文住宅 T様邸新築工事 内装下地工事進捗
-

かっこいいのにあたたかい♪足場板とアイアンの家具をオーダー
-

総社・岡山 新築木造 注文住宅 進捗状況
-

岡山の木造住宅なら!延床面積約27坪・3LDK/北側道路の旗竿地専用。サンオリエントの間取りプラン紹介No.72
-

倉敷市船穂町での構造見学会&手形式 ありがとうございました!!
-

岡山県倉敷市注文住宅 T様邸新築工事 内部下地工事の方順調に進んでます!
-

トイレの壁にこだわってみる~倉敷市船穂T様邸~
-

総社・岡山注文木造住宅 着工と進捗!
-

岡山の木造住宅なら!木造住宅間取りプラン・延床面積24坪・北道路/コンパクトでリーズナブル!サンオリエントの木造住宅プランNo.71
-

地鎮祭のヒ・ミ・ツ 注文住宅新築のイロハ@岡山
-

岡山県倉敷市注文住宅 T様邸新築工事 サッシ取付・遮熱材貼り施工!
-

夏涼しい家にするコツは?~倉敷市船穂の構造見学会で~
-

岡山県総社市注文住宅 Y様邸新築工事 内装仕上工事
-

岡山の木造住宅なら!間取りプラン・延床面積約25坪,2階リビング/コンパクトでリーズナブル!サンオリエントの木造住宅プランNo.70
-

もしもこの世から結露とカビを無くせたなら~遮熱工法の可能性
-

岡山県倉敷市注文住宅 T様邸新築工事 内部構造材取付・屋根葺き
-

岡山での注文住宅 契約後の変更?できますか!
-

岡山の木造住宅なら!間取りプラン・延床面積約25坪,北道路/コンパクトでリーズナブル!サンオリエントの木造住宅プランNo.69
-

「ザ・男の職場!!」と見せかけ女性大歓迎(^o^)岡山の注文住宅建てませんか?
-

岡山県倉敷市注文住宅 T様邸新築工事 上棟しました!
-

フツウの家じゃつまんない!方必見!構造見学会開催!
-

岡山県総社市注文住宅 Y様邸新築工事 内装下地工事
-

岡山の木造住宅なら!木造住宅間取りプラン・延床面積30坪/自然派ライフスタイルの方におすすめ!サンオリエントの木造住宅プランNo.68
-

岡山県倉敷市注文住宅 T様邸新築工事 内部打ち放しRC壁施工
-

我が家に必要な収納スペースって?新築の時に持ち物を見直そう!
-

岡山県総社市注文住宅 Y様邸新築工事 外装・内部下地
-

岡山の木造住宅なら!木造住宅間取りプラン・延床面積26坪/自然派ライフスタイルの方におすすめ!サンオリエントの木造住宅プランNo.67
-

岡山県倉敷市注文住宅 T様邸新築工事 基礎工事進捗状況
-

マツコの知らない、、、で紹介された後藤飲料水工業所へ行ってきました
-

岡山で美味いうどんが食べたい その17(讃岐も近いしね)
-

岡山の木造住宅なら!木造住宅間取りプラン・延床面積約35坪/屋上テラスやグリーンゲージ。サンオリエントの木造住宅プランNo.66
-

岡山でRC住宅を建てるなら!「RCの防音効果について」 連載コラムその17
-

岡山の木造住宅なら!木造住宅間取りプラン・延床面積約32坪/屋上テラスやグリーンゲージ。サンオリエントの木造住宅プランNo.65
-

新築住宅の構造見学会@岡山県総社市 思い出作りはいかがですか??(^_^)
-

岡山県倉敷市注文住宅 T様邸新築工事 今日から基礎工事スタートしました!
-

岡山の木造住宅にコンクリートを使用しオシャレでデザイン性のある家に
-

住宅のビフォアーアフターを楽しもう!~構造見学会開催~@総社市
-

岡山県総社市注文住宅 Y様邸新築工事 建方(棟上)
-

岡山の木造住宅なら!木造住宅間取りプラン・延床面積25坪以下/屋上テラスやグリーンゲージ。サンオリエントの木造住宅プランNo.64
-

倉敷市玉島黒崎新町にオススメの空き部屋出ました@RCマンション
-

木造注文住宅の構造見学会開催!@総社市
-

岡山県総社市注文住宅 Y様邸新築工事 建方準備
-

岡山の木造住宅なら!木造住宅間取りプラン・延床面積約32坪/スキップフロアでたっぷり収納。サンオリエントの木造住宅プランNo.63
-

岡山県倉敷市木造注文住宅 T様邸新築工事 地鎮祭
-

岡山で注文住宅を建てる~タイル選び~
-

岡山県総社市注文住宅 Y様邸新築工事 基礎コンクリート工事
-

岡山の木造住宅なら!木造住宅間取りプラン・延床面積約30坪/スキップフロアでたっぷり収納。サンオリエントの木造住宅プランNo.62
-

「シックハウスの対策はどうするの?」連載コラムその15
-

雨天時の墨出しは憂鬱になります。。。その理由とは?
-

岡山でこんな自然素材の家を建てませんか?
-

岡山県総社市注文住宅 Y様邸新築工事 基礎配筋工事
-

岡山の木造住宅なら!木造住宅間取りプラン・延床面積約30坪/使いやすい家事動線や間取りが特徴。サンオリエントの木造住宅プランNo.61
-

建築道具紹介~天井や壁に物を取付たいけど下地がいない・・・。そんな時はコイツを使います!
-

注文住宅って?@岡山県総社市の木造注文住宅
-

岡山県総社市注文住宅 Y様邸新築工事 いよいよ工事着工です!
-

岡山の木造住宅なら!木造住宅間取りプラン・延床面積約30坪/使いやすい家事動線や間取りが特徴。サンオリエントの木造住宅プランNo.60
-

建築道具紹介~高機能な便利アイテム レーザー墨出し器とは?
-

北欧食器を使ったテーブルコーディネート~おしゃれに見えるディスプレイのコツ③~
-

岡山の注文住宅や当社の工事進捗状況
-

岡山の木造住宅なら!木造住宅間取りプラン・延床面積約37坪/使いやすい家事動線や間取りが特徴。サンオリエントの木造住宅プランNo.59
-

建築道具紹介~建築現場での作業時水平・垂直を確認する道具とは?
-

お施主様の声~岡山注文住宅 K様邸~
-

岡山市中区湊での公共工事(小規模工事)が始まりました
-

岡山の木造住宅なら!木造住宅間取りプラン・延床面積約30坪/使いやすい家事動線や間取りが特徴。サンオリエントの木造住宅プランNo.58
-

建築道具紹介~RC建築現場でコンクリート打設前に打ち込むインサートとは?
-

サンワカンパニー大阪ショールームへ行ってきました!<キッチン編>
-

岡山市 リフォーム後の故障!! 早速修理にお伺いしました
-

岡山の木造住宅なら!木造住宅間取りプラン・延床面積約32坪/北側道路の旗竿地専用プラン。サンオリエントの木造住宅プランNo.57
-

「マジかよ!?」と、つい言いたくなる衝撃の住宅設備の秘密@岡山の注文住宅
-

建築道具紹介~RC造でサッシ取付時の必需品!
-

岡山・倉敷の注文住宅~インダストリアル&コンクリートのT様邸~
-

岡山市中区 注文住宅用土地情報 解体工事始まりました。
-

岡山の木造住宅なら!木造住宅間取りプラン・延床面積27坪/コンパクトでリーズナブル!サンオリエントの木造住宅プランNo.56
-

新築木造アパート「アーバンテラス津島福居」 すべての工事が完了しました!
-

「ひな祭り」のテーブルコーディネート&インテリア
-

岡山木造注文住宅 地盤調査を行いました
-

岡山の木造住宅なら!木造住宅間取りプラン・延床面積25坪以下/コンパクトでリーズナブル!サンオリエントの木造住宅プランNo.55
-

「シックハウス症候群は要因別の対策が必要」連載コラムその13
-

テレビのベストサイズって?@岡山市北区の家で検証
-

岡山の新築木造アパート「アーバンテラス津島福居」 駐輪場の設置を行いました!
-

韓国薬膳料理教室に行ってきました@倉敷市上東「韓国料理焼肉ペンナル」
-

工事現場で役立つスマホアプリの紹介,岡山の新築・リフォーム、RC・木造住宅などで!
-

岡山の木造住宅なら!木造住宅間取りプラン・延床面積25坪以下/コンパクトでリーズナブル!サンオリエントの木造住宅プランNo.54
-

お風呂と屋根のリフォームで高評価頂きました!!
-

岡山の新築木造アパート「アーバンテラス津島福居」 まもなく完成です!
-

岡山で住宅・マンションのアフターフォローに行きました フィッシングショー大阪に行ってきました
-

岡山の木造住宅なら!木造住宅間取りプラン・延床面積約30坪/自然派ライフスタイルの方におすすめ!サンオリエントの木造住宅プランNo.53
-

連載コラムその12 「シックハウス症候群にかかるとどうなるの?」
-

アーバンテラス津島福居新築工事 外部足場解体~屋外階段取付!
-

岡山から考えてみた 築地・豊洲問題 について
-

岡山の木造住宅なら!木造住宅間取りプラン・延床面積23坪/自然派ライフスタイルの方におすすめ!サンオリエントの木造住宅プランNo.52
-

連載コラムその11 「新築でシックハウス症候群になる原因は?」
-

アーバンテラス津島福居新築工事 進捗状況(2017/01/27)
-

お打合せの様子 ~Y様邸~木造注文住宅@岡山県総社市
-

新築木造住宅などの塗装は何が良いか? 岡山発
-

3LDK・南道路/延床面積約25坪☆岡山で木造住宅を建てるなら!サンオリエントの新築住宅プランNo.51☆自然派ライフスタイルの方におすすめの家「エコロジア」
-

アーバンテラス津島福居新築工事 外壁張り完了~内装工事進捗状況!
-

魚焼きグリルは必要?不要?~岡山で家を建てる~
-

岡山県倉敷市に大規模木造新築物件完成!
-

北道路・2階リビング・3LDK/延床面積約32坪☆岡山で木造住宅を建てるなら!サンオリエントの新築住宅プランNo.50☆グリーンゲージのある家「ガーデン」
-

岡山で新築住宅をお考えのアナタに質問!! 「日常と非日常どっち??」
-

アーバンテラス津島福居新築工事 進捗状況!
-

サンオリエントで家づくりすると「3つのイイコト」があります②
-

岡山で美味いうどんが食べたい その16(讃岐も近いしね)
-

北道路・2階リビング・3LDK/延床面積約27坪☆岡山で木造住宅を建てるなら!サンオリエントの新築住宅プランNo.49☆グリーンゲージのある家「ガーデン」
-

「謹賀新年」 明けましておめでとうございます!! 新年早々見舞われた珍事とは・・・?
-

年末年始のアーバンテラス津島福居新築工事の進捗状況!
-

新年あけましておめでとうございます
-

お正月のテーブルコーディネート~おしゃれに見えるディスプレイのコツ②~
-

岡山で美味いうどんが食べたい その15(讃岐も近いしね)
-

健康自然素材『音響熟成木材』。一年中素足で気持ちいい・音響熟成木材うづくりの床☆岡山で新築住宅を建てるなら!サンオリエントの自然素材No.8☆
-

人気の「伊島小学校&京山中学校区」54坪の更地です。ついにベールを脱ぐ激レア物件!!
-

建築現場での工種別道具紹介♪ その3
-

サンオリエントで家づくりすると「3つのイイコト」があります①
-

岡山で美味いうどんが食べたい その14(讃岐も近いしね)
-

健康自然素材『音響熟成木材』。住まいを森のような空気にする木材・音響熟成木材☆岡山で新築住宅を建てるなら!サンオリエントの自然素材No.7☆
-

連載コラムその10 「アレルギーの原因を取り除く!?漆喰の効果」
-

アーバンテラス津島福居新築工事 内部造作 進捗状況
-

クリスマスのテーブルコーディネート~おしゃれに見えるディスプレイのコツ①~
-

岡山で美味いうどんが食べたい その13(讃岐も近いしね)
-

健康自然素材『音響熟成木材』。木材の質を保つ乾燥法「音響熟成」による防菌・防カビ作用☆岡山で新築住宅を建てるなら!サンオリエントの自然素材No.6☆
-

連載コラムその9 「壁紙の上から漆喰を塗る内装リフォームの手順」
-

「焼肉レストラン千屋牛」@岡山県新見市正田でお食事&ショッピング
-

岡山での新築 耐震補強金物はどんなものを使う?のか
-

健康自然素材『音響熟成木材』。南九州産の杉が原木として使われる理由。☆岡山で新築住宅を建てるなら!サンオリエントの自然素材No.5☆
-

連載コラムその8 「漆喰にカビが生えた!?その対策と予防法」
-

アーバンテラス津島福居新築工事 進捗状況(2016/12/02)
-

岡山建築探訪②安藤忠雄設計「高梁市成羽美術館」~草間彌生の世界展~
-

岡山で日曜大工の道具選び(ドリル) ファジアーノ岡山PO決勝進出!!
-

健康自然素材『幻の漆喰』。漆喰がもつ、見過ごされがちな高いデザイン性。☆岡山で新築住宅を建てるなら!サンオリエントの自然素材No.4☆
-

アーバンテラス津島福居新築工事 外壁面リフレクティックス貼り!
-

新築時にチェックしたい大切なこと~岡山で家を建てる~
-

健康自然素材『幻の漆喰』。化学物質を吸着・分解する「光熱触媒」の効果。☆岡山で新築住宅を建てるなら!サンオリエントの自然素材No.3☆
-

連載コラムその6 岡山で住宅をお考えのあなたに「漆喰の特徴と住宅に取り入れるメリット」
-

アーバンテラス津島福居新築工事 木造建方完了!
-

ピアノの防音対策♪「静床ライト」の効果と音漏れはどう?@岡山
-

頑張れファジアーノ岡山 最終戦PO進出!
-

健康自然素材『幻の漆喰』。「光熱触媒」作用で室内の空気を清浄化。☆岡山で新築住宅を建てるなら!サンオリエントの自然素材No.2☆
-

今度のイベントは一味違うぞ!!岡山で住宅や工場などの「断熱・遮熱」を本気で考えているあなたへ朗報!!
-

アーバンテラス津島福居新築工事 進捗状況
-

岡山で新築やリフォームするなら、知っておいた方が絶対!トクするセミナー開催! 2016/11/10(木) Blog 岡山 リフォーム 工務店
-

岡山で美味いうどんが食べたい その12(讃岐も近いしね) ファジアーノ岡山水戸戦
-

岡山市立福浜中学校ピタコラム工事完了しました!
-

健康自然素材『幻の漆喰』。完全天然素材の安全な壁材です。☆岡山で新築住宅を建てるなら!サンオリエントの自然素材No.1☆
-

連載コラムその5 岡山で住宅をお考えのあなたに「木材の乾燥方法、自然乾燥材と人工乾燥材の違い」
-

岡山市中区 A様邸浴室改修工事 施工状況!
-

構造見学会&安心して暮らせる家づくりセミナー開催 11/26~27 岡山市北区津島福居
-

岡山市中区1級建築士事務所 建築士の違い?
-

3LDK・屋上テラス/延床面積約30坪☆岡山で木造住宅を建てるなら!サンオリエントの新築住宅プランNo.48☆ルーフテラスで贅沢な時間を堪能できる家「ガーデン」
-

オススメ!岡山で住宅をお考えのあなたに「木造住宅(在来工法)の工程と工期の目安」
-

岡山市立福浜中学校ピタコラム工事 1階コンクリート打設~1階型枠解体!
-

ハロウィン&秋のインテリア例
-

倉敷のS様邸 竣工1年検査に行って来ました
-

3LDK・ルーフテラス/延床面積約27坪☆岡山で木造住宅を建てるなら!サンオリエントの新築住宅プランNo.47☆グリーンゲージのある家「ガーデン」
-

岡山で住みたい街No1はどこ?→不動の1位はやっぱり津島(京山学区)?
-

岡山市立福浜中学校ピタコラム工事 1階型枠建込!
-

ピアノを二階に搬入&費用は?@岡山市北区
-

ファジアーノ岡山セレッソ戦に行ってきました!
-

4LDK+スキップフロア/延床面積35坪☆岡山で木造住宅を建てるなら!サンオリエントの新築住宅プランNo.46☆中2階のある家「スキップ」
-

オススメ!岡山で住宅をお考えのあなたへ「日本の気候と風土に適した木造住宅の特徴」
-

岡山市立福浜中学校ピタコラム 型枠工事スタート!
-

ピアノの防音対策♪「静床ライト」を敷いてみた@岡山市
-

岡山から大阪まで行ってきました。
-

2LDK将来3LDK/延床面積約27坪☆岡山で木造住宅を建てるなら!サンオリエントの新築住宅プランNo.45☆収納や趣味のスペース・中2階のある家「スキップ」
-

オススメ!岡山で住宅をお考えのあなたへ 「木造の寿命が30年は本当?」 2016/10/10(月) Blog 木造住宅の寿命
-

岡山市立福浜中学校ピタコラム工事 鋼板建方完了!
-

秋のおでかけ「岡山の安富牧場」&リフォーム見学会へレッツゴー♪
-

3LDK+和室・吹き抜け/延床面積約35坪☆岡山で木造住宅を建てるなら!サンオリエントの新築住宅プランNo.44☆子育て世代におすすめの「ファミリアル」
-

必見!岡山で住宅をお考えのあなたへ 「木造住宅のメリットとデメリット」
-

岡山市 福浜中学校ピタコラム工事 鋼板建方が始まりました!
-

2階リビング・北道路/延床面積約33坪☆岡山で木造住宅を建てるなら!サンオリエントの新築住宅プランNo.43☆子育て世代におすすめの「ファミリアル」
-

自然素材を使った「空気がうまい家」リフォーム完成見学会開催 @ 岡山市北区足守
-

岡山市福浜中学校ピタコラム工事 進捗状況
-

2階リビング・3LDK/延床面積約37坪☆岡山で木造住宅を建てるなら!サンオリエントの新築住宅プランNo.42☆子育て世代におすすめの「ファミリアル」
-

2階リビング・3LDK/延床面積約37坪☆岡山で木造住宅を建てるなら!サンオリエントの新築住宅プランNo.42☆子育て世代におすすめの「ファミリアル」
-

スウェーデン式サウンディング試験生中継@岡山木造アパート
-

スウェーデン式サウンディング試験生中継@岡山木造アパート
-

岡山市 福浜中学校 ピタコラム工事が始まりました!
-

岡山市 福浜中学校 ピタコラム工事が始まりました!
-

おもちゃの収納例♪イオン岡山『CRASH GATEクラッシュゲート』で家具購入
-

北道路・4LDK+和室/延床面積約30坪☆岡山で木造住宅を建てるなら!サンオリエントの新築住宅プランNo.41☆子育て世代におすすめの「ファミリアル」
-

当社施工RC住宅物件へのご案内@岡山市北区
-

県道江崎金岡線道路改良工事 まもなく工事完了まで進んでおります!
-

リフォーム完成!岡山市北区 I 様邸 タカラスタンダード『ホーローシステムキッチン』の口コミ
-

北玄関・2階リビング・L字型土地/延床面積25坪以下☆岡山で木造住宅を建てるなら!サンオリエントの新築住宅プランNo.40☆広々バルコニーのある家「ノース」
-

岡山市 旭操小学校修繕工事完了しました!
-

岡山市倉敷市で住宅用土地探しのご相談も承ります
-

北道路・2階リビング/延床面積約30坪☆岡山で木造住宅を建てるなら!サンオリエントの新築住宅プランNo.39☆北玄関専用の家「ノース」
-

競売生情報!@岡山 「強制執行完了の巻」 この現場は天国だ!と言われたその真相は??
-

完成見学会(@岡山市中区倉田)への多数のご参加ありがとうございました!!
-

岡山市古都小学校ピタコラム工事 コンクリート打設!
-

岡山で夏涼しい家を建てよう!エアコン代節約♪省エネな新築一戸建て見学会
-

岡山 新築物件 遮熱住宅仕様リフレクトホーム (竣工)
-

北道路・2階リビング/延床面積27坪☆岡山で木造住宅を建てるなら!サンオリエントの新築住宅プランNo.38☆「コンパクト」でシンプルライフを満喫
-

RC住宅@岡山 そもそもコンクリートって地産地消って知ってる?その3
-

岡山市 古都小学校 ピタコラム工事 型枠工事が始まりました!
-

岡山で自然素材の家を建てる~岡山市中区倉田で新築完成見学会~
-

岡山 新築物件 遮熱住宅仕様リフレクトホーム (外部仕上)
-

RC住宅@岡山 そもそもコンクリートって地産地消って知ってる?その2
-

岡山市立古都小学校ピタコラム補強工事 鋼板取付が完了しました!
-

新築完成見学会 岡山市中区倉田 8月27日(土)28(日)
-

岡山 新築物件 遮熱住宅仕様リフレクトホーム (仕上)
-

北道路・2階リビング/延床面積25坪以下☆岡山で木造住宅を建てるなら!サンオリエントの新築住宅プランNo.37☆「コンパクト」でシンプルライフを満喫
-

RC住宅@岡山 そもそもコンクリートって地産地消って知ってる!?
-

小学校の修繕工事
-

岡山市北区 遮熱材(リフレクティックス)・自然素材(自然建材) 住宅リフォーム 工事状況 3
-

北道路・3LDK・独立型キッチン/延床面積27坪☆岡山で木造住宅を建てるなら!サンオリエントの新築住宅プランNo.36☆「コンパクト」でシンプルライフを満喫
-

毎年夏恒例の耐震補強工事(ピタコラム工法)が始まりました!
-

『競売耳よりニュース』 @岡山 競売の落札後はどうなる??続報その2
-

浴室リフォーム完成!岡山市北区 I 様邸 タカラスタンダード『レラージュ』の口コミ
-

岡山市北区 遮熱材(リフレクティックス)・自然素材(自然建材) 住宅リフォーム 工事状況 2
-

1LDK・2Fワンフロア/延床面積25坪以下☆岡山で木造住宅を建てるなら!サンオリエントの新築住宅プランNo.35☆「コンパクト」でシンプルライフを満喫
-

岡山で「家を新築」と言えば・・・、に変化が起きるかな?
-

岡山 新築物件 遮熱住宅仕様リフレクトホーム 進捗状況
-

住宅ローンへの不安・・・いくら借りる?岡山市中区での住宅イベントにて。
-

岡山市北区 遮熱材(リフレクティックス)・自然素材(自然建材) 住宅リフォーム 工事状況
-

シンプルライフを満喫するコンパクトでも暮らしやすい開放的な家。「コンパクト」☆岡山で木造住宅を建てるなら!サンオリエントの新築住宅プランNo.34☆
-

イギリスのEU離脱決定! 遠く離れたこの岡山で、これを家造りにどう生かす?その3
-

岡山 新築物件 遮熱住宅仕様リフレクトホーム(遮熱材貼り)
-

京山学区で土地探し&新築&岡山市中区倉田で新築見学会します
-

岡山 新築物件 遮熱住宅仕様リフレクトホーム (上棟)
-

4LDK・広い玄関/延床面積約37坪☆岡山で木造住宅を建てるなら!サンオリエントの新築住宅プランNo.33☆自然派ライフスタイルの方におすすめの家「エコロジア」
-

自社事務所屋根への遮熱材「リフレクティックス」施工完了しました!
-

夏涼しい家!新築見学会開催 (岡山市中区倉田 7月16日17日)
-

岡山 新築物件 遮熱住宅仕様リフレクトホーム (基礎 2)
-

新築現場見学会@岡山市中区倉田 エアコン一台で家中涼しいってホント?
-

3LDK+和室・東西道路/延床面積約32坪☆岡山で木造住宅を建てるなら!サンオリエントの新築住宅プランNo.32☆自然派ライフスタイルの方におすすめの家「エコロジア」
-

岡山で美味いうどんが食べたい その11(讃岐も近いしね)
-

遮熱材「リフレクティックス」を自社事務所の屋根に施工中です!
-

岡山市北区でリフォーム始まる!漆喰・床暖房・断熱・タカラキッチン&バス・内窓など盛りだくさん!
-

岡山 新築物件 遮熱住宅仕様リフレクトホーム (基礎)
-

1階リビング・北道路/延床面積約30坪☆岡山で木造住宅を建てるなら!サンオリエントの新築住宅プランNo.31☆自然派ライフスタイルの方におすすめの家「エコロジア」
-

工事現場の安全は常に祈ります! @岡山
-

岡山で家を建てるなら当社へ、パソコン教室はディードットステーション下中野教室へ!
-

岡山で美味いうどんが食べたい 番外編(四国ラーメン事情)
-

県道江崎金岡線道路改良工事 進捗状況&今年も梅雨の時期がきました(-_-;)
-

新築するならピアノのことも考えて~岡山のこどもピアノ教室~
-

岡山ではいまいち盛り上がりに欠ける遮熱材「リフレクティックス」全国規模で見るととんでもないことになってます!
-

岡山から阪神タイガースの応援に行ってみました。
-

1階リビング・東西道路/延床面積約23坪☆岡山で木造住宅を建てるなら!サンオリエントの新築住宅プランNo.30☆自然の力で空気循環が行える家「エコロジア」
-

競売開札速報@岡山地裁&競売の落札後はどうなる??続報
-

岡山で美味いうどんが食べたい その10(讃岐も近いしね)
-

県道江崎金岡線道路改良工事(28-1) 現場進捗状況
-

岡山で土地探し!に行き詰ったら。「ドリームマップ」を作ってみよう!
-

ファジアーノ岡山VS松本山雅 試合プレビュー 首位攻防戦!!
-

太陽、風、自然の力を活かし、空気循環を行える家。「エコロジア」☆岡山で木造住宅を建てるなら!サンオリエントの新築住宅プランNo.29☆
-

岡山で美味いうどんが食べたい その9(讃岐も近いしね)
-

遮熱工法の勉強&免許取得のため福島県まで行ってきました!
-

「家づくりノート」を作ろう!岡山で新築!土地探し! 始めにすることは<その2>
-

岡山で遮熱材 リフレクティックス を採用しました&ホームベーカリー
-

1階リビング・北道路/延床面積約25坪☆岡山で木造住宅を建てるなら!サンオリエントの新築住宅プランNo.28☆庭を取り込んだ家「ガーデン」
-

当社のRC住宅が記事として掲載されました!&おかげさまで岡山で13年
-

岡山で美味いうどんが食べたい その8(讃岐も近いしね)
-

岡山市N様邸にてピザ窯初火入れ&試食会にお邪魔してきました!
-

炭酸水メーカーのコストパフォーマンスは?太陽光発電にもつながる話。
-

岡山で今しなくてはいけないことは?・・・岡山での地震・津波の被害を考えてみた
-

1階リビング・南道路/延床面積約35坪☆岡山で木造住宅を建てるなら!サンオリエントの新築住宅プランNo.27☆庭を取り込んだ家「ガーデン」
-

消費税再増税延期決定? 家造りをお考えの方に影響は@岡山
-

岡山で美味いうどんが食べたい その7(讃岐も近いしね)
-

岡山市 N様邸 ピザ窯作り後編!
-

暑い夏に向けてオススメ!炭酸水メーカー「ソーダストリーム・クリスタル」
-

ファジ暫定2位 岡山で美味いうどんが食べたい その6(讃岐も近いしね)&ファジアーノ岡山 愛媛FC戦
-

2階リビング・ルーフテラス/延床面積約30坪☆岡山で木造住宅を建てるなら!サンオリエントの新築住宅プランNo.26☆庭を取り込んだ家「ガーデン」
-

気になる「競売物件」 落札したらその後どうなる? 岡山で競売を検討しているあなたへ!
-

住宅新商品発表会&懇親会お疲れ様でした!!@岡山ロイヤルホテル
-

N様邸にてピザ窯作りがスタートしました!
-

heimtextail トレンドセミナー in サンゲツ岡山
-

岡山で美味いうどんが食べたい その5(讃岐も近いしね)&ファジアーノ岡山 FC岐阜戦
-

2階リビング・北道路/延床面積約30坪☆岡山で木造住宅を建てるなら!サンオリエントの新築住宅プランNo.25☆庭を取り込んだ家「ガーデン」
-

熊本・大分を襲った地震から学ぶべき事は?~岡山で自分たちが出来る事 Vol.3
-

県道江崎金岡線道路改良工事 着工しました!
-

建築専門雑誌に載った貴重な住宅をリノベーション!岡山市中区にて見学会開催!
-

タカラ岡山ショールームで 「住宅セミナー」 ありますよ♪
-

岡山で美味いうどんが食べたい その4(讃岐も近いしね)&早明浦ダムでバスフィッシング
-

2階リビング・ルーフテラス/延床面積約25坪☆岡山で木造住宅を建てるなら!サンオリエントの新築住宅プランNo.24☆庭を取り込んだ家「ガーデン」
-

熊本・大分を襲った地震から学ぶべき事は?~岡山で自分たちが出来る事 Vol.2
-

今週の迷言 「電話しよっかな~?」子育て日記より
-

今年のGW休みは井原の岡山西ゴルフ倶楽部に行ってきました!
-

岡山から久万高原ラリー&四国カルストに行ってみました。
-

熊本・大分を襲った地震から学ぶべきなのは?~岡山で自分たちが出来る事
-

お詫びm(_ _)m
-

建築現場での工種別道具紹介♪その2
-

岡山市で新築!土地探し! 始めにすることは?
-

岡山で美味いうどんが食べたい その3(讃岐も近いしね) & パン作り
-

庭を建物の内側に取り込んだグリーンゲージのある家「ガーデン」☆岡山で木造住宅を建てるなら!サンオリエントの新築住宅プランNo.23☆
-

【競売開札速報】 今月の岡山地方裁判所物件 見事落札か?
-

岡山で遮熱技術勉強会開催 その2 あの有名店舗も遮熱でハッピーに!?
-

岡山で遮熱技術の勉強会開催! しかしのっけからテストが・・・
-

建築現場での工種別道具紹介♪ その1
-

4月23日、24日 岡山市中区 「住まいづくりフェア」開催
-

岡山で日本棚田百選に行ってきました&岡山の耐震
-

北道路・中2階/延床面積約40坪☆岡山で木造住宅を建てるなら!サンオリエントの新築住宅プランNo.22☆たっぷり収納スペースのある家「スキップ」
-

それでもあなたは家賃と同じ返済額で家を建てますか?
-

名紙「けんちく新聞」パクられたか? 岡山の書店「啓文社」のシブ過ぎる演出!!
-

Pray for Kumamoto
-

岡山で美味いうどんが食べたい その2(讃岐も近いしね)
-

ピタコラム工事の現地確認へ行ってきました!
-

4月23日24日 家づくりイベントで「家づくりのスペシャリスト」になろう♪ 岡山市中区湊にて
-

岡山から福島県へセミナーを受けに行ってきました。
-

速報!! どうなった住宅ローン金利!? ちなみに岡山は?
-

南道路・スキップフロア/延床面積35坪☆岡山で木造住宅を建てるなら!サンオリエントの新築住宅プランNo.21☆たっぷりの収納スペースのある家「スキップ」
-

「けんちく新聞」 from 岡山市中区のあたたかリノベーションの家より
-

「Osera’s Style」第二弾!! 岡山市中区のあたたかリノベーション取材決行
-

TOHOシネマズ岡南にて4D映画初体験してきました!
-

漆喰の壁の汚れ落とし <赤ワイン編> ~岡山市北区 朝日の家~
-

岡山で美味いうどんが食べたい その1(讃岐も近いしね) ファジアーノ岡山東京ヴェルディ戦結果
-

東西道路・スキップフロア/延床面積約32坪☆岡山で木造住宅を建てるなら!サンオリエントの新築住宅プランNo.20☆中2階のある家「スキップ」
-

アパートの家賃並で家が建つ! にだまされるな! **子供の為**に建てた家で子供と離ればなれにならない為に
-

今週の迷言 「よんがつになったら俺は小鹿になる!」 子育て日記より
-

岡山も桜が開花しました!
-

岡山で春を感じました
-

北道路・スキップフロア/延床面積24坪☆岡山で木造住宅を建てるなら!サンオリエントの新築住宅プランNo.19☆中2階のある家「スキップ」
-

消費税が上がろうが上がるまいが。 **子供の為**「岡山で家を建てるタイミングは?」
-

今週の迷言「箸は落とすから箸はやらん!」 子育て日記より
-

特殊建築物等定期調査・建築設備定期検査とは?
-

子どもとお出かけ おとなも楽しめる!≪カバヤ岡山工場≫ 岡山市北区御津
-

岡山国際サーキット SUPER GT 公式テスト・ファン感謝デーに行ってきました
-

南道路・スキップフロア/延床面積24坪☆岡山で木造住宅を建てるなら!サンオリエントの新築住宅プランNo.18☆中2階のある家「スキップ」
-

岡山で遮熱工事をお考えなら当社へ! リフレクティックスの面白実験公開中!!
-

岡山の競売開票速報!! 競売物件で土地や建物を仕入れるのも一つの選択肢です!!
-

建物の現地調査・実測はこんな感じで行っています!
-

おしゃれな〝見せる収納” ② 岡山市北区のコンクリート住宅での実例を紹介します
-

岡山の年度末工事 SUPER GT 公式テスト ファン感謝デー
-

収納や趣味のスペースを確保した中2階のある家「スキップ」☆岡山で木造住宅を建てるなら!サンオリエントの新築住宅プランNo.17☆
-

岡山で希少なRC住宅 OB宅見学会 多数のご参加ありがとうございました!!
-

倉敷シーサイドホテル研修棟耐震補強工事 外部足場解体しました!
-

岡山のコンクリート建築探訪 ① 前川國男設計:天神山文化プラザ
-

岡山 古民家改修調査に行ってきました
-

2階リビング・南道路/延床面積約35坪☆岡山で木造住宅を建てるなら!サンオリエントの新築住宅プランNo.16☆子育て世代にもおすすめ木造住宅「ファミリアル」
-

知りたい事の答えが満載!岡山でRC住宅の見学会ならココ!!
-

倉敷シーサイドホテル研修棟耐震補強工事 外部塗装工事スタート!
-

“見せる収納”のコツ <キッチン編>
-

Jリーグ開幕 ファジアーノ岡山開幕戦 (対レノファ山口アウェー戦)
-

RC住宅「コンクリートモデル」 延床面積約32坪/3LDK(和室)☆岡山でRC住宅を建てるなら!サンオリエントの新築住宅プランNo.15☆
-

岡山で遮熱工法をお考えなら当社へ!! リフレクティクスのおもしろテスト公開(^o^)
-

倉敷シーサイドホテル研修棟耐震補強工事 仕上工事スタート!
-

岡山市北区芳賀でコンクリート住宅見学会開催!2016年3月12日13日
-

輸入壁紙で植木鉢カバーを簡単手作り!&オセラに掲載されました!
-

岡山発 住まいの傷を安価で直すDIY講座 フローリング編
-

RC住宅「コンクリートモデル」 延床面積約32坪/3LDK☆岡山でRC住宅を建てるなら!サンオリエントの新築住宅プランNo.14☆
-

遂に公開、リフレクティクスのチカラ!!岡山で断熱?いやいや遮熱でいきましょう!!
-

倉敷シーサイドホテル研修棟耐震補強工事 内部鉄骨ブレス補強工事!
-

岡山市で人気の住宅は? 「戸建注文住宅商品開発アンケート」集計結果発表!
-

岡山発 住まいの傷を安価で直すDIY講座 壁紙編 SUPER GT 脇坂寿一引退!
-

2階リビング・北道路/延床面積約35坪☆岡山で木造住宅を建てるなら!サンオリエントの新築住宅プランNo.13☆子育て世代にもおすすめ木造住宅「ファミリアル」
-

日銀マイナス金利導入によって何が起きるのか!? 住宅ローンと賢くつきあう方法
-

倉敷シーサイドホテル研修棟耐震補強工事 ピタコラムコンクリート打設!
-

岡山からフィッシングショー大阪2016に行ってきました
-

1Fリビング・南道路/延床面積約32坪☆岡山で木造住宅を建てるなら!サンオリエントの新築住宅プランNo.12☆子育て世代にもおすすめ木造住宅「ファミリアル」
-

熾烈な住宅ローン戦争激化 変動金利vs固定金利
-

イベントへのご参加ありがとうございました!! 岡山の照明センターショールームにて!!
-

高級絨毯「ギャッベ」をお得に手に入れる方法!?
-

倉敷シーサイドホテル研修棟耐震補強工事 開口閉塞部生コン打設!
-

玄関マットにオススメ!ギャッベの使い心地は?岡山市北区照明センターでギャッベに触れてみた♪
-

今週末お得なイベント行います!! 照明器具や高級絨毯ギャッベを割安で手に入れよう(^o^)
-

岡山でRC住宅を建てたい RC住宅とは?その9 最終回 (フィッシングショー大阪2016)
-

1Fリビング・東西道路/延床面積約30坪☆岡山で木造住宅を建てるなら!サンオリエントの新築住宅プランNo.11☆子育て世代にもおすすめ木造住宅「ファミリアル」
-

転勤・転校などの引っ越しシーズン到来!! 耳寄りな賃貸情報のお知らせ(^_^)
-

倉敷シーサイドホテル研修棟耐震補強工事 ピタコラム鋼板建方!
-

岡山で新築! アルミサッシの結露対策 ~浴室の換気扇をまわしておくと、、、~
-

岡山でRC住宅を建てたい RC住宅とは?その8 (RC住宅頼む会社は?の巻)
-

カウンターキッチンから見渡せるリビングダイニング。子育て世代にもおすすめ木造住宅プラン「ファミリアル」☆岡山で木造住宅を建てるなら!サンオリエントの新築住宅プランNo.10☆
-

イベントへの参加ありがとうございました!! 爆弾低気圧にも負けない、晴れっぷり!!移住するなら岡山へ(^O^)/
-

イベント2日目開催中!! 爆弾低気圧もはねのけて、さすが晴れの国岡山!!
-

岡山でモデルハウスオーナーになりませんか!? イベント開催中(^O^)/
-

倉敷シーサイドホテル研修棟耐震補強工事 進捗状況!
-

ファジアーノ岡山2016チーム紹介 加入選手紹介
-

2Fリビング・北玄関/延床面積約25坪☆岡山で木造住宅を建てるなら!サンオリエントの新築住宅プランNo.9☆広々としたバルコニーのある家。北玄関専用プラン「ノース」
-

岡山でモデルハウスオーナーに!! イベント会場のタカラのチカラ ホーロー製品の知られざる実力とは!?
-

倉敷シーサイドホテル研修棟耐震補強工事 進捗状況!
-

岡山でオトクに家を建てよう!モデルハウスオーナー募集のお知らせ
-

モデルハウスオーナー募集説明会開催!タカラ岡山ショールーム 1月23日、24日
-

岡山でRC住宅を建てたい RC住宅とは?その7 (RC住宅何処に頼むの巻)
-

2Fリビング,北玄関木造住宅プラン「ノース」。広々としたバルコニーのある家☆岡山で木造住宅を建てるなら!サンオリエントの新築住宅プランNo.8☆
-

住宅ローンを通したいのに通らない(>_<) 注意しなければいけない大事な事 その3
-

倉敷シーサイドホテル 耐震補強工事 現場進捗状況!
-

岡山で子どもとおでかけ 【池田動物園】
-

岡山でRC住宅を建てたい RC住宅とは?その6 (RCの長所短所の巻)
-

2Fリビング・北玄関/延床面積約35坪☆岡山で木造住宅を建てるなら!サンオリエントの新築住宅プランNo.7☆ゆったりとした前庭のある家。北玄関専用プラン「ノース」
-

住宅ローンを通したいのに通らない(>_<) のお話しの続きの予定でしたが、まずは明けましておめでとうございます!!
-

2Fリビング・北玄関/延床面積約27坪☆岡山で木造住宅を建てるなら!サンオリエントの新築住宅プランNo.6☆ゆったりとした前庭のある家。北玄関専用プラン「ノース」
-

住宅ローンを通したいのに通らない(>_<) 注意しなければいけない大事な事!
-

倉敷シーサイドホテル研修棟耐震補強工事 現場進捗状況!
-

岡山でのXmasイベント「整理収納セミナー」大好評でした!
-

岡山でRC住宅を建てたい RC住宅とは?その5 (ゼネコンの巻)
-

2Fリビング,北玄関木造住宅プラン「ノース」。ゆったりとした前庭のある家☆岡山で木造住宅を建てるなら!サンオリエントの新築住宅プランNo.5☆
-

家の新築をお考えの方に!フラット35の金利引下げ特例終了迫る!!
-

倉敷シーサイドホテル研修棟耐震補強工事 外部足場組進行中です!
-

風邪の季節にオススメアロマ リードディフューザーを手作り!
-

岡山でRC住宅を建てたい RC住宅とは?その4 (ゼネコンの巻前編)
-

2Fリビング・北玄関/延床面積25坪☆岡山で木造住宅を建てるなら!サンオリエントの新築住宅プランNo.4☆リビングから見通せるバルコニーのある家。北玄関専用プラン「ノース」
-

コンベックス岡山にて 断熱・遮熱技術セミナーに参加してきました!
-

倉敷市児島にある倉敷シーサイドホテルの耐震補強工事始まりました!
-

岡山市北区奥田で整理収納セミナー&アロマ作り講座を開催します
-

岡山でRC住宅を建てたい RC住宅とは?その3 (構造1本化の巻)
-

2Fリビング,北玄関木造住宅「ノース」。リビングから見通せるバルコニーのある家☆岡山で木造住宅を建てるなら!サンオリエントの新築住宅プランNo.3☆
-

児島にて民間工事のピタコラム耐震補強第一弾です!!
-

岡山市にて昨年竣工した鉄骨造住宅の1年点検に行ってきました!
-

書類の整理方法&【特別予告】岡山「整理収納セミナー」開催!
-

岡山でRC住宅を建てたい RC住宅とは?その2 (住宅ハウスメーカーの巻)
-

2Fリビング,北玄関専用木造住宅プラン「ノース」☆岡山で木造住宅を建てるなら!サンオリエントの新築住宅プランNo.2☆
-

岡山で家を建てる時に知っておきたい地盤の事 その2サウンディング試験編
-

11月28日リクシル岡山ショールームにて新商品発表会を行いました!
-

岡山の吉備高原CCに行ってきました!
-

新築イベントのお知らせ<第3弾>11月28日(土) リクシル岡山ショールームにて
-

岡山でRC住宅を建てたい RC住宅とは?その1
-

北玄関や2Fリビング、屋上テラスや中2階のあるプランなど。☆岡山で木造住宅を建てるなら!サンオリエントの新築住宅プランNo.1☆
-

岡山で住宅を建てるなら!アンケートにご協力頂きまして誠にありがとうございますm(_ _)m
-

現場管理業務あれこれ 工程管理
-

岡山で新築イベント開催です。11月28日(土)リクシル岡山ショールーム
-

ファジアーノ岡山ホーム最終戦セレモニー レビュー
-

岡山で家を建てる時に知っておきたい事 建物も人生も足元が大事!!
-

工事写真撮影時の便利道具♪
-

岡山 駅前商店街でワインとお寿司 食べ放題! Nakasuji [ナカスジ]
-

着工前申請業務あれこれ 確認申請書
-

建築現場の仕事あれこれ ほんの一部を紹介します!! 「施工図編」 その2
-

メンテナンス道具で手軽に補修
-

ガスとIH、どっちがオススメ?
-

サッカーJリーグ ファジアーノ岡山
-

建築現場の仕事あれこれ ほんの一部を紹介します!!
-

わたしの趣味
-

輸入壁紙で冷蔵庫をかんたんリメイク
-

岡山発 ボートでブラックバス釣り ボート牽引の話
-

岡山市立御南中学校でのピタコラム工事と津軽海峡冬景色
-

【岡山/耐震補強工事(ピタコラム工法)】毎夏恒例のピタコラム工事!
-

七五三写真撮影 @ 倉敷フォトスタジオ⁺
-

【岡山/完成物件 メンテナンス】
-

[岡山・県道江崎金岡線道路改良工事 完成!!]
-

【岡山/N様邸リノヴェーション工事】玄関の解体工事を行いました!
-

【岡山/N様邸リノヴェーション工事】 番外編♪ 『建築新聞』
-

【岡山/N様邸リノヴェーション工事】 内装工事進行中
-

【岡山/県道江崎金岡線道路改修工事】 暑い夏だったけれど・・・
-

【岡山/仏心寺礼拝所新築工事】 できました!!
-

【岡山/F様邸リノヴェーション工事】 完成!
-

【岡山/N様邸リノヴェーション工事】 母屋工事
-

【岡山/ピタコラム工事】2015年度
-

【岡山/県道江崎金岡線改良工事】道路改良工事
-

【岡山/S様邸新築工事】 お引き渡し
-

【岡山/仏心寺礼拝所新築工事】 進捗状況
-

【岡山/仏心寺礼拝所新築工事】 内装工事進捗状況
-

【岡山/F様邸リノヴェーション工事】 建具
-

【岡山/仏心寺礼拝所新築工事】 外部塗装
-

【岡山/N様邸リノヴェーション工事】 解体着工
-

【岡山/仏心寺礼拝所新築工事】 屋根瓦葺き
-

【岡山/仏心寺礼拝所新築工事】 現場進捗状況
-

【岡山/S様邸新築工事】 外部整地
-

【岡山/仏心寺礼拝所新築工事】 内装仕上材
-

【岡山/S様邸新築工事】 外部足場解体! 内装工事!
-

【岡山/仏心寺礼拝所新築工事】 土間コンクリート打設
-

【岡山/仏心寺礼拝所新築工事】 上棟!!
-

【岡山/仏心寺礼拝所新築工事】 基礎コンクリート打設
-

【岡山/S様邸新築工事】 内部工事…次は仕上げだ!!
-

【岡山/仏心寺礼拝所新築工事】 解体工事
-

【岡山/S様邸新築工事】 内装工事
-

【岡山/S様邸新築工事】 外壁サイディング工事
-

【岡山/仏心寺礼拝所新築工事】 解体工事開始
-

【岡山/S様邸新築工事】 見えなくなるところにこんな秘密が…
-

【岡山/S様邸新築工事】 瑕疵担保保険検査
-

【岡山/S様邸新築工事】 上棟
-

【岡山/S様邸新築工事】 足場組立
-

【岡山/S様邸新築工事】 基礎工事進行中!!
-

【岡山/S様邸新築工事】 地鎮祭
-

Facebookはじめました!!!
もっと見る
Sunorient
Sunorient
Sunorient
Sunorient
Sunorient
Sunorient
Sunorient
Sunorient
Contact お問い合わせ
住まいに関するご依頼・ご相談・ご質問など
お気軽にお問い合わせください。









